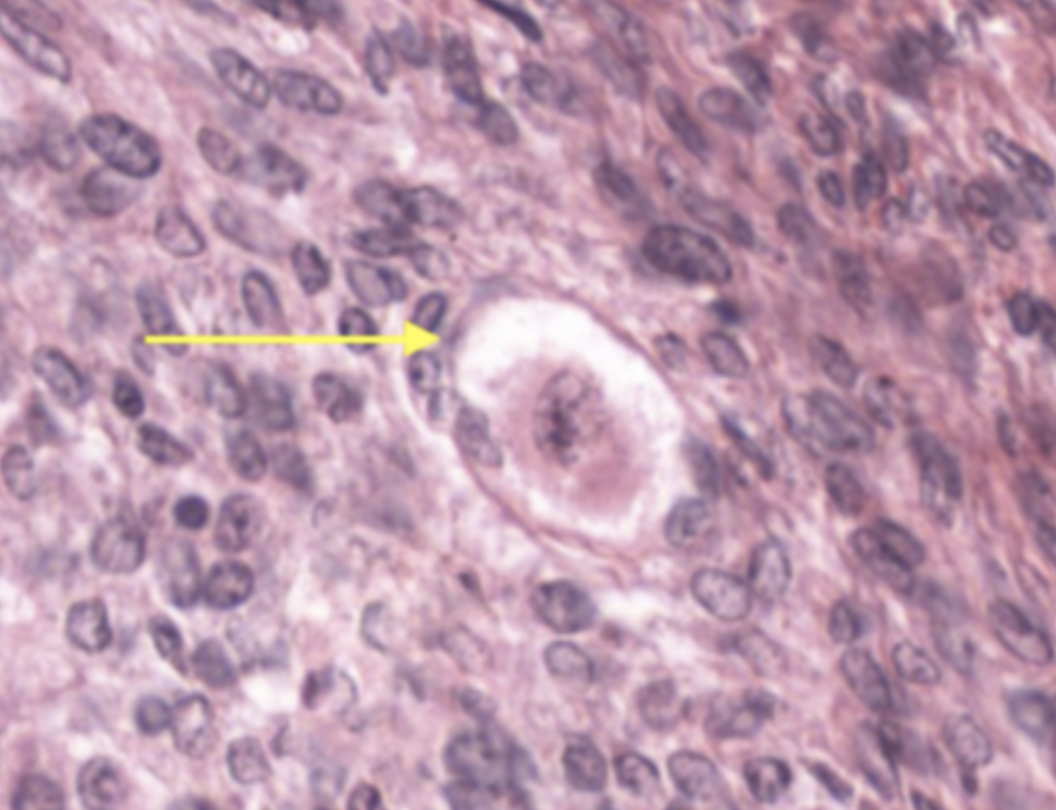
term image

lab quiz last histo
1/44
There's no tags or description
Looks like no tags are added yet.
Name | Mastery | Learn | Test | Matching | Spaced | Call with Kai |
|---|
No analytics yet
Send a link to your students to track their progress
45 Terms

Ovary

Primordial follicle
Oocyte
follicular cell

What stage
Primary follicle

oocyte
Zona pellucida
Zona Granulosa

Primordial follicle (simple squamous)

Primordial follicle (simple squamous)
Primordial follicle

Growing follicle

What type of follicle? stage?
Secondary follicles

yellow
antrum

blue
oocyte

red
zona granulosa

Green
Zona Pellucida

Identify the stage of the follicle
Graafian follicle

Stage the follicle : Secondary follicle
Identify THE SPECIFIC REGION OR SPACE: : the antrum

secondary
primary

first box
theca interna

Lactating mammary gland

Lactating mammary gland

cervix

identify the organ and stage
uterus and secretory

granulosa lutein cell

theca lutein cell

theca lutein cell

yellow and red
theca lutein cell and granulosa lutein cell

Granulosa lutein cell

uterus

whole structure
fallopian tube (fimbriae)

fimbriae

Menstrual uterus

secretory uterus

Identify the stage of the organ
secretory uterus

proliferating uterus

follicular antrum

Identify the cell
primary oocyte

Identify the layer
Theca

identify the cell
Follicular cell

Identify the layer
theca

Identify the layer
stratum granulosum

zona pellucida

identify the organ
non-lactating mammary gland

identify the mucosa
vaginal mucosa

identify the mucosa
Vaginal mucosa

identify the mucosa
vaginal mucosa
stratified squamous epithelium
lamina propria